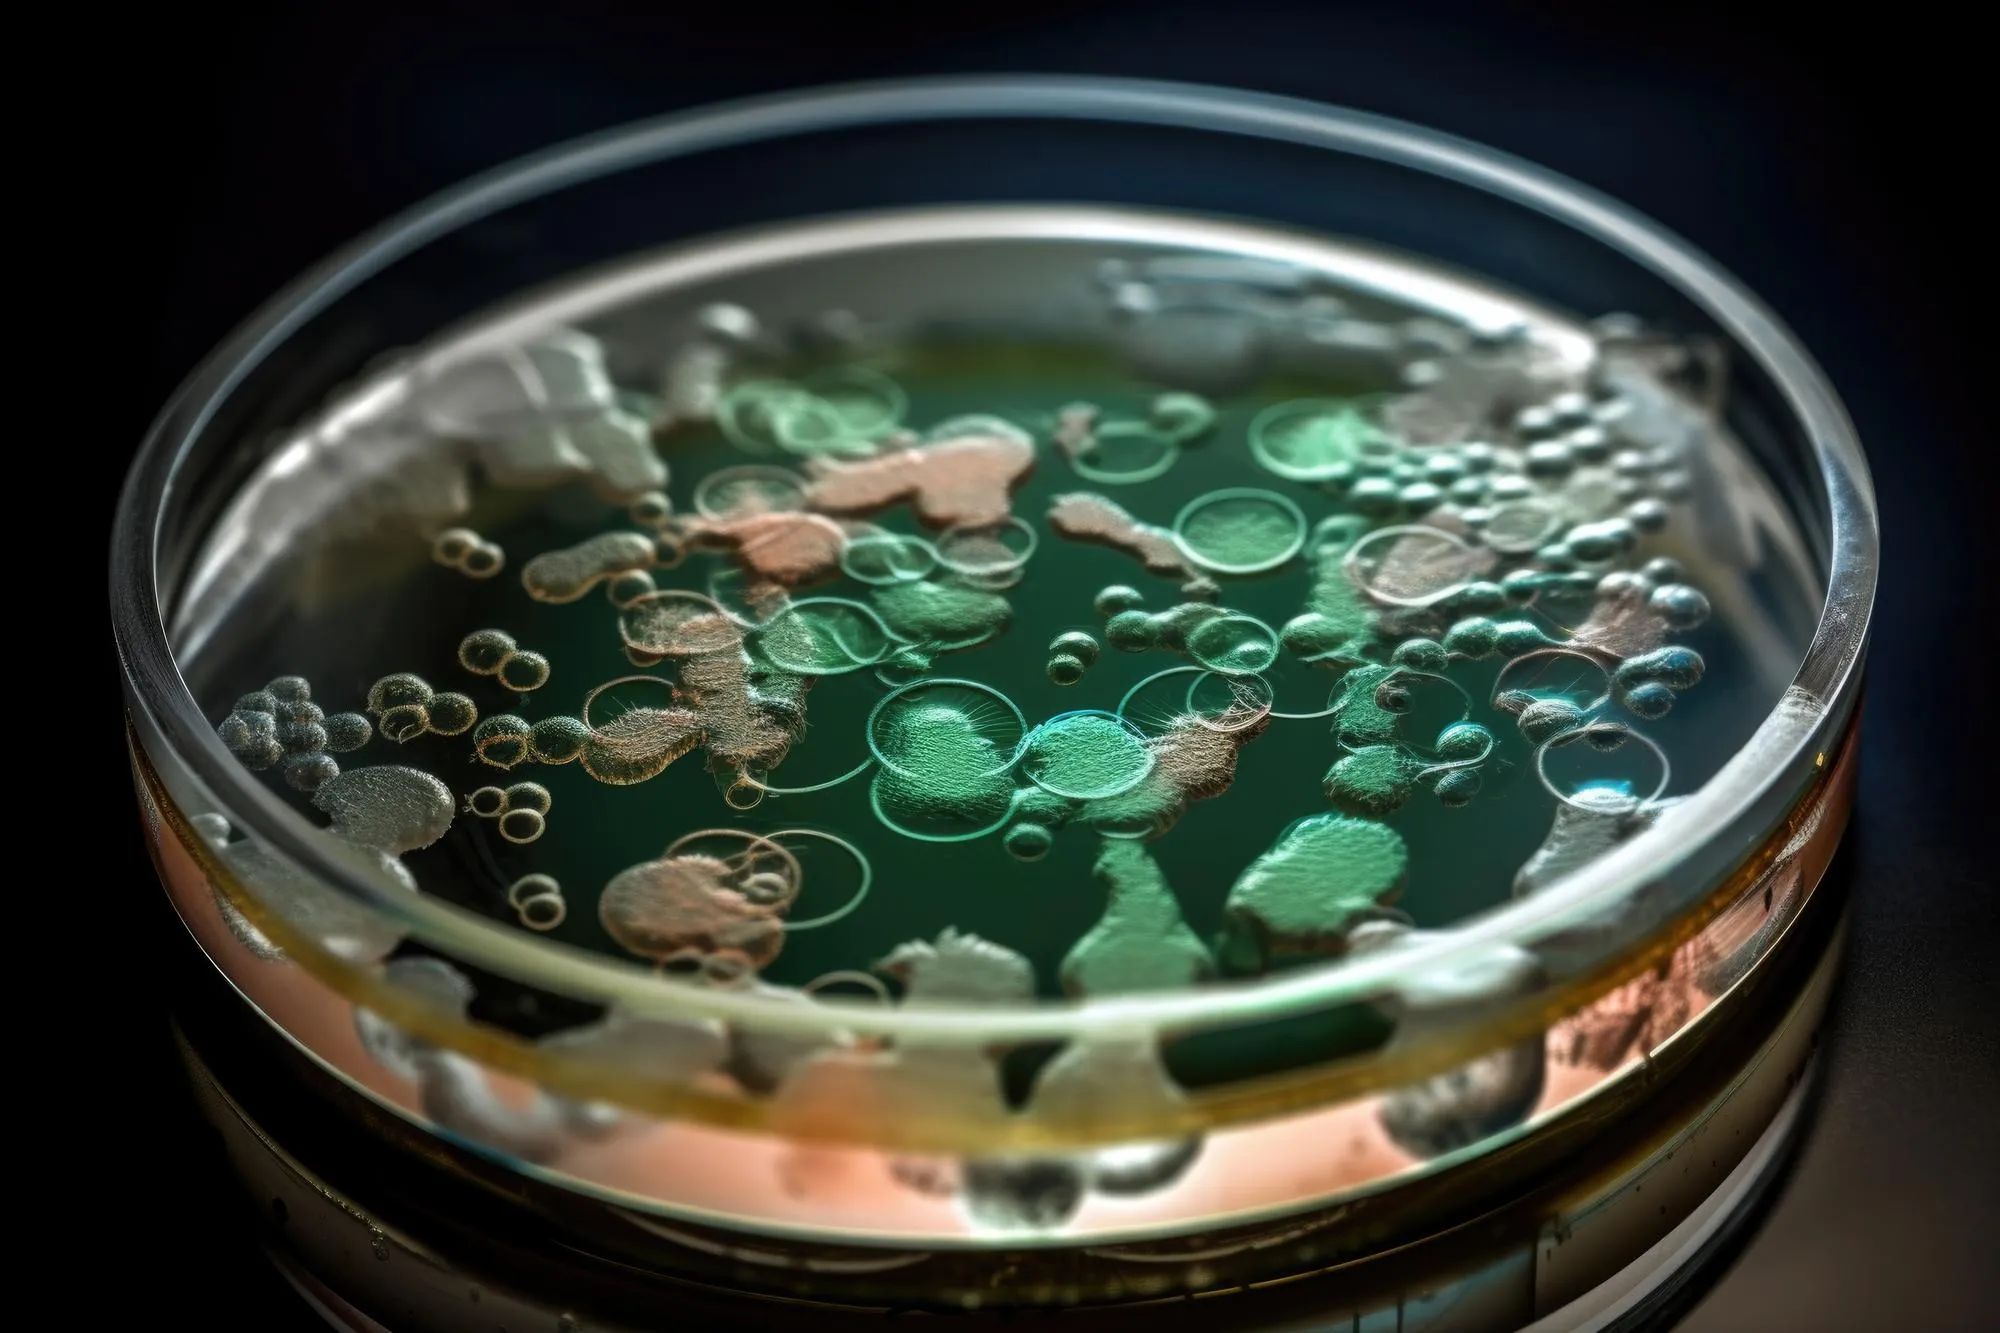
antibiotics

In an extraordinary leap forward for antimicrobial research, a groundbreaking study published in the esteemed “Peptides” journal revealed that bioengineering could significantly bolster the specificity and stability of the antimicrobial peptides, Nisin and Rombocin. Spearheaded by a distinguished team of scientists from the University of Groningen, this study has set a new precedent in the fight against antibiotic-resistant pathogens.
The lantibiotic group of antimicrobial peptides, with Nisin as its prototype, is well known for its broad-spectrum inhibition against Gram-positive bacteria. This capacity holds immense potential in managing food-borne pathogens and poses a formidable challenge to clinically relevant antibiotic-resistant strains. Due to Nisin’s gene-encoded nature, gene-based bioengineering has allowed for the production of novel derivatives with enhanced functional properties.
The focal point of this study is the engineering of uncommon amino acid residues dehydroalanine (Dha) and dehydrobutyrine (Dhb), integral in the unique mechanism through which these peptides wage war against harmful bacteria. The study identified that the site-specific incorporation of these dehydrated amino acid residues could significantly augment the peptides’ activity. Led by Guo Longcheng, Stoffels Konstantin, Broos Jaap, and Kuipers Oscar P from the Groningen Biomolecular Sciences and Biotechnology Institute, the team successfully enhanced peptide dehydration efficiency through a novel expression system leveraging the nisin modification machinery, NisBTC.
This meticulous research process involved comparing the antimicrobial activity of the nisin and rombocin peptides containing the dehydrated amino acids Dha and Dhb. Particularly for rombocin, a shorter variant of nisin, the presence of Dhb at residue position 18 resulted in an activity fourfold greater than its non-dehydrated counterpart, against the strain Lactococcus lactis. It also emerged that in both peptides, Dha was more potent than Dhb at the same position.
When the researchers purified the wild-type nisin and its engineered variant nisinG18/Dha, minimum inhibitory concentration (MIC) testing demonstrated that the variant’s activity closely paralleled that of wild-type nisin in restraining Bacillus cereus growth. However, it revealed a doubled MIC against four other tested Gram-positive strains, indicating an improved performance.
Further stability assessments under varying temperatures revealed that the engineered variant matched wild-type nisin’s resilience but exhibited greater resistance to proteolytic enzymes. This feature could potentially translate into a longer shelf-life and a more extended functional period within biological systems after administration.
The study’s findings, now cemented in scientific literature with a DOI: 10.1016/j.peptides.2024.171152, have substantial implications for the medical and food industries. Enhancing the potency of nisin and rombocin not only offers a promising strategy to combat antibiotic resistance but also supports food preservation methods, thus reducing spoilage and foodborne illnesses.
References
1. Guo L., Stoffels K., Broos, J., & Kuipers O. P. (2024). Altering Specificity and Enhancing Stability of the Antimicrobial Peptides Nisin and Rombocin through Dehydrated Amino Acid Residue Engineering. Peptides, 174, 171152. https://doi.org/10.1016/j.peptides.2024.171152
2. Field, D., O’Connor, P. M., Cotter, P. D., Hill, C., & Ross, R. P. (2016). Bioengineering of the Model Lantibiotic Nisin. Bioengineered, 7(3), 171-178. https://doi.org/10.1080/21655979.2016.1146732
3. Zhang, Q., Yu, Y., Velasquez, J. E., & van der Donk, W. A. (2012). Evolution of lanthipeptide synthetases. Proceedings of the National Academy of Sciences, 109(45), 18361-18366. https://doi.org/10.1073/pnas.1210391109
4. Arnison, P. G., Bibb, M. J., Bierbaum, G., Bowers, A. A., Bugni, T. S., Bulaj, G., … & Van Der Donk, W. A. (2013). Ribosomally synthesized and post-translationally modified peptide natural products: overview and recommendations for a universal nomenclature. Natural Product Reports, 30(1), 108-160. https://doi.org/10.1039/C2NP20085F
5. Dischinger, J., Basi Chipalu, S., & Bierbaum, G. (2014). Lantibiotics: Promising candidates for future applications in health care. International Journal of Medical Microbiology, 304(1), 51-62. https://doi.org/10.1016/j.ijmm.2013.11.011
Declaration of competing interest: The authors have professed no conflicts of interest regarding the content of this article.
Keywords
1. Antimicrobial Peptides Engineering
2. Nisin and Rombocin Efficacy
3. Dehydrated Amino Acid Residue
4. Antibiotic-Resistant Pathogens Control
5. Lantibiotics Stability Enhancement
In conclusion, this study marks a significant advance in the selective engineering of antimicrobial peptides, offering hope for more effective strategies against superbugs, which could pave the way for innovative treatments and preservatives. As such, the broader implications on public health and food safety could be immense, warranting further exploration and development of this promising technology.